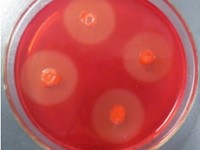

信息中心
芦荟的组培方法和材料
芦荟的繁殖一般采用分株法或芽插法,繁殖系数低,而且受到季节的限制。利用组织培养诱导愈伤组织和丛生芽,再进行继代扩大培养,在短期内可获得大量种源,并可常年生产,特别在引进新品种时,更能显示它的优越性。
《自然》杂志论文:水——一个持久的秘密
没人真正地了解水。 承认这个问题是很尴尬的。但是报道我们的行星的三分之二的物质,仍然是个奥秘。更坏的是,我们关注得越多,积累的问题就越多:新技术更深入探查液体水分子建筑学,产生更多难题。
我用羟基磷灰石做转染,基因转染中荧光照片有问题
我用羟基磷灰石做转染,转染了48小时,用的是绿色荧光蛋白籽粒,拍出来的荧光照片是这样 是不是我的籽粒没转染成功 没在细胞内表达 还是没释放完全表达的太弱 请高手指教啊
菌种复壮,诱变但结果还是不尽人意怎么办?
本人做得是细菌转化实验,年前上罐的单位都在20000以上,年后用同样的斜面活化后再上罐单位始终在15000左右徘徊,我们拿原来的菌株做过了复壮,诱变但结果还是不尽人意,甘油管,斜面,种子还有发酵都是重复的年前实验也是不行。往各位高手们多指教。
纤维素分解菌用英语怎么说?
纤维素分解菌用英语怎么表达?我看有的用cellulose degrader,有的用cellulose decomposer,到底哪个更专业?或者说有没有一个专有的名词?
PAUP(windows版本)构建NJ树时用什么命令?
Zui近用PAUP构建了NJ树,因为对这方面不太懂,Zui后发现输入的命令可能有问题,分支长度没有区别,并且substitution/site值也不对,别人文献里基本都是0.01,而我的确是10,我用的命令见下,求高人指导。
用索氏提取法提的粗脂肪,可以直接做甲酯化吗?
常规饲料分析是用乙醚浸提样品所得的乙醚浸出物。粗脂肪中除真脂肪外,还含有其他溶于乙醚的有机物质,如叶绿素、胡萝卜素、有机酸、树脂、脂溶性维生素等物质,故称粗脂肪或乙醚浸出物。
做有机污染物的微生物降解过程中有看到过透明圈的现象吗?
大家做有机污染物的微生物降解过程中有看到过透明圈的现象吗?我做Pyrene的时候都没有见过透明圈的现象,不过我是将溶解在助溶剂的Pyrene直接加在固体平板上,然后晃平就是没有采取其他的办法。我是将Pyrene作为唯一碳源的。
氧化亚铁硫杆菌和氧化硫硫杆菌的染色计数方法
Zui近我要做微生物淋滤实验,现在已经大致从底泥中分离出了这两种微生物。从文献中查到T.f和Tt分别用草酸铵结晶紫和石碳酸复红染色。
pKD46 pKD13和pCP20这三个质粒哪里有啊?
需要敲除革兰氏阴性细菌一基因,因试验室之前没人做,白手起家,现在急需pKD46 pKD13和pCP20这三个质粒,不知哪位实验室里有啊,能否惠赠?
M13K07的扩增方法?下一步要提取单链DNA
因为冰箱里的M13好长时间了,想扩增一下,并于下一步提取单链DNA。谁有比较详细的扩增方法阿?不要说分子克隆上的,那个有点乱。